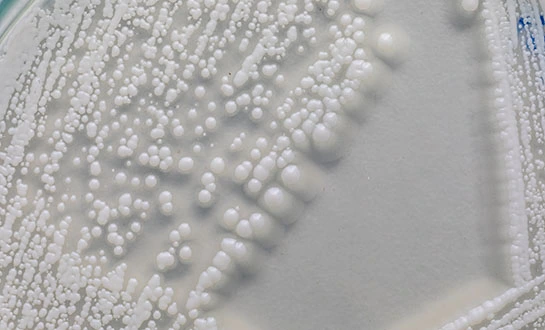
yeast peptide fertilizer

Why Yeast-Derived Biostimulants Are Gaining Attention
As agriculture faces increasing pressure to improve productivity while reducing environmental impact, biostimulants are receiving growing attention worldwide. Among them, yeast-derived biostimulants stand out as environmentally compatible alternatives to conventional chemical fertilizers, offering measurable improvements in crop performance and soil health.
Derived from natural yeast components and cellular fractions, these biological products support plant growth, enhance stress tolerance, and contribute to sustainable soil systems. As awareness of biostimulants increases among growers and agribusiness stakeholders, global demand continues to expand, particularly in production systems seeking efficiency, regulatory compliance, and long-term sustainability.
Understanding Yeast-Derived Biostimulants in Modern Agriculture
Yeast-derived biostimulants encompass a broad category of biological inputs designed to enhance plant physiological processes rather than supply nutrients directly. Their effects are achieved through biological interactions at both plant and soil levels.
Definition and Functional Scope of Biostimulants
Biostimulants are substances or microorganisms that stimulate natural plant processes to improve nutrient uptake, stress tolerance, and overall crop quality. Unlike traditional fertilizers, yeast-based biostimulants act primarily through metabolic regulation and biological signaling pathways.
Role of Yeast-Based Inputs in Crop Systems
Yeast-derived products utilize bioactive compounds such as amino acids, peptides, carbohydrates, and vitamins to support root development, nutrient assimilation, and plant defense responses. These properties make them suitable for integration into diverse agricultural systems, including conventional, sustainable, and organic production models.
Scientific Basis of Yeast-Derived Biostimulant Technology
The effectiveness of yeast-derived biostimulants is supported by well-documented biochemical and physiological mechanisms. Their bioactivity originates from the natural composition of yeast cells and the processing technologies used to extract functional compounds.
Bioactive Components and Their Functions
Yeast-based biostimulants contain amino acids and peptides that contribute directly to protein synthesis and metabolic signaling. Vitamins and carbohydrates support enzymatic activity and energy transfer, while yeast cell wall components such as beta-glucans and mannans are known to activate plant defense responses.
In addition, enzymatic hydrolysis processes generate small-molecule peptides with high bioavailability, allowing efficient absorption and utilization by plant tissues.
Mechanisms of Action in Plant and Soil Systems
Once applied, yeast-derived biostimulants interact with plant cells to enhance nutrient transport, improve stress recovery, and regulate growth responses. Amino acids serve as both building blocks and signaling molecules, while nucleotides accelerate cellular repair processes during environmental stress.
At the soil level, these products promote microbial diversity and activity, contributing to improved nutrient cycling and long-term soil structure. This dual plant–soil interaction is a key factor distinguishing biostimulants from conventional agrochemical inputs.

Drivers Behind the Growing Adoption of Yeast-Derived Biostimulants
The rapid expansion of the biostimulants market is driven by a combination of environmental, regulatory, economic, and technological factors.
Environmental and Regulatory Pressures
Increasing restrictions on chemical fertilizer and pesticide use have accelerated interest in biological alternatives. Governments and regulatory bodies worldwide are promoting sustainable agricultural practices, creating favorable conditions for biostimulants that align with environmental protection goals.
Consumer demand for sustainably produced food further reinforces this trend, encouraging growers to adopt inputs that reduce ecological impact while maintaining productivity.
Economic and Agronomic Incentives
From an economic perspective, yeast-derived biostimulants often improve nutrient use efficiency, reducing the need for additional fertilizer inputs. Enhanced crop resilience and quality can also contribute to more stable yields and improved market value.
Field studies and commercial trials across a range of crops—including vegetables, fruits, and field crops—have demonstrated improvements in stress tolerance, growth uniformity, and soil biological activity, supporting broader adoption.
Procurement Considerations for Yeast-Derived Biostimulants
For B2B stakeholders, selecting appropriate biostimulants requires careful evaluation of product characteristics, supplier capabilities, and application compatibility.
Product Evaluation Criteria
Key parameters include the concentration of bioactive compounds such as free amino acids, peptides, and vitamins. Products with higher proportions of small-molecule peptides generally exhibit superior bioavailability and more consistent plant responses.
Stability under varying storage and temperature conditions is critical for global distribution. Compatibility with fertilizers, pesticides, and other crop inputs is also essential for operational efficiency.
Supplier Capabilities and Quality Assurance
Established manufacturers differentiate themselves through advanced enzymatic processing technologies, robust quality control systems, and transparent product specifications. Production capacity and supply consistency are particularly important for large-scale distributors, formulators, and OEM clients.
Reliable suppliers also provide technical documentation, regulatory support, and application guidance to ensure compliance with regional standards and end-user requirements.

Application Best Practices and Program Integration
Maximizing the benefits of yeast-derived biostimulants depends on appropriate application strategies aligned with crop physiology and environmental conditions.
Application Timing and Dosage Strategies
Early-season applications support root establishment and early vigor, while mid-season treatments enhance nutrient uptake during critical growth stages. Post-stress applications are commonly used to accelerate recovery from heat, drought, or salinity stress.
Dosage recommendations vary by crop, growth stage, and formulation. For many field crops, foliar application rates in the range of 2–4 L/ha are effective, while greenhouse and specialty crops may require adjusted programs.
Integration with Existing Agricultural Systems
Yeast-derived biostimulants are typically used in conjunction with standard fertilization programs, improving nutrient efficiency and reducing overall input demand. Their compatibility with precision agriculture technologies allows targeted application and optimized resource use.
Performance monitoring through tissue analysis, soil testing, and yield evaluation supports continuous program optimization and data-driven procurement decisions.
Conclusion
Yeast-derived biostimulants represent a significant advancement in modern agricultural input strategies. By combining biological activity, environmental compatibility, and agronomic effectiveness, they address key challenges faced by today’s farming systems.
As scientific validation continues to expand and regulatory frameworks increasingly support biological solutions, yeast-based biostimulants are positioned to play an important role in the transition toward more sustainable and resilient agricultural practices worldwide.

FAQ
Q1: What differentiates yeast-derived biostimulants from other biological products?
Yeast-derived biostimulants contain unique combinations of amino acids, peptides, nucleotides, and cell wall components that act synergistically to enhance plant metabolism and stress response. Their enzymatically produced small-molecule peptides offer high bioavailability compared to larger protein-based products.
Q2: Are yeast-derived biostimulants suitable for organic agriculture?
Many yeast-derived products meet organic certification requirements when produced from approved sources and processed without synthetic chemicals. Certification status depends on regional standards and should be verified with suppliers.
Q3: How do cost considerations influence procurement decisions?
Although unit costs may be higher than conventional fertilizers, overall program costs are often reduced through improved nutrient efficiency and crop performance. Bulk purchasing and long-term supply agreements further improve cost-effectiveness.
Q4: Can yeast-derived biostimulants be used with precision agriculture systems?
Yes. Modern formulations are compatible with precision application technologies, including fertigation and variable-rate systems, enabling accurate dosing without equipment issues.
Contact LYS for Premium Biostimulants Solutions
Agricultural professionals seeking reliable yeast-derived solutions can partner with LYS to access cutting-edge formulation technologies and comprehensive technical support. Our experienced team provides customized consultation services for biostimulants procurement, helping distributors and OEM clients optimize their product portfolios with proven biological enhancers. Request detailed product specifications, pricing information, and sample materials to evaluate our Amino Acid Peptide Solution YPD300 for your specific applications. Connect with our technical experts at alice@aminoacidfertilizer.com to discuss bulk purchasing options and explore partnership opportunities.
References
1. Martinez, R. et al. "Yeast-Derived Biostimulants: Mechanisms of Action and Agricultural Applications." Journal of Agricultural Science, vol. 158, no. 3, 2023, pp. 245-262.
2. Thompson, K.L. and Rodriguez, M.A. "Small Molecule Peptides in Plant Nutrition: Bioavailability and Metabolic Impact." Plant Physiology and Biochemistry, vol. 185, 2022, pp. 78-89.
3. Chen, W. et al. "Enzymatic Hydrolysis Techniques for Enhanced Bioactive Compound Recovery from Yeast." Food and Bioprocess Technology, vol. 16, no. 4, 2023, pp. 892-908.
4. Anderson, P.J. "Sustainable Agriculture Through Biological Stimulants: Market Trends and Future Prospects." Agricultural Economics Review, vol. 41, no. 2, 2022, pp. 156-171.
5. Kumar, S. and Zhang, L. "Stress Tolerance Enhancement in Crops Using Yeast-Based Formulations." Crop Science, vol. 63, no. 1, 2023, pp. 89-104.
6. Williams, D.R. et al. "Regulatory Frameworks for Biostimulants: Global Perspectives and Implementation Guidelines." Regulatory Affairs Professionals Society Journal, vol. 28, no. 3, 2022, pp. 334-349.

Tell us your needs — we’ll provide the right solution for your crops and markets.

Innovating Agriculture with Yeast-Derived Amino Acid Peptides



